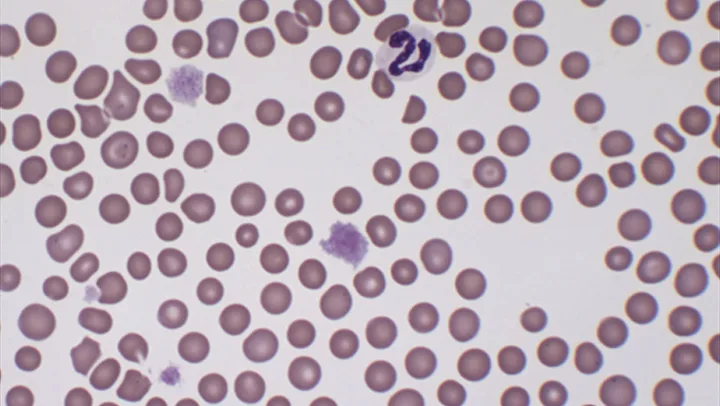
Featured Image
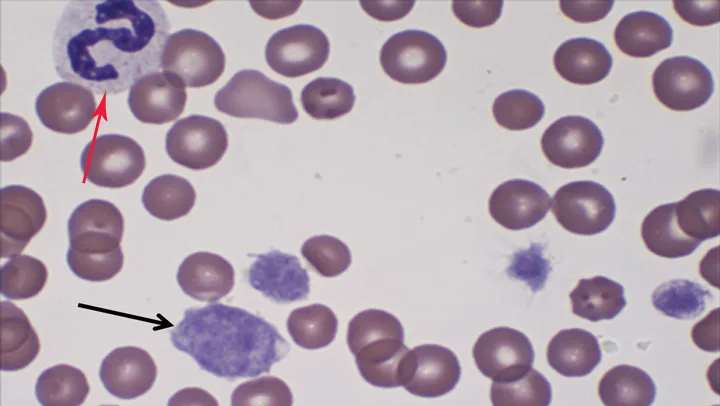
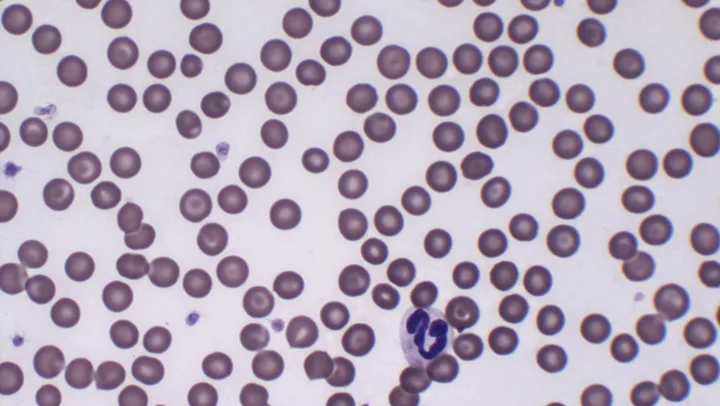
Featured Image

Macrothrombocytopenia in a Cavalier King Charles Spaniel

A 6-year-old neutered Cavalier King Charles spaniel was presented with a 2-week history of difficulty climbing stairs and jumping into the car.
History
The Cavalier King Charles spaniel (CKCS) had a previous diagnosis of a grade III/VI left systolic heart murmur.
Physical Examination
The heart murmur as previously described was detected. Instability in the left stifle was also noted. The remainder of the examination was unremarkable.
Laboratory Evaluation
CBC was unremarkable with the exception of an automated platelet count of 2350/µL (reference interval, 181–525 ¥ 103/µL; Cell-Dyn 3500 hematology analyzer using impedance technology for platelet count). A blood smear was evaluated.
Related Article: What Your Hematology Analyzer Can't Tell You
Ask Yourself?
What should you take into consideration when evaluating platelet counts in CKCSs?
What is a potential pitfall with automated platelet counts?
What test could you complete in your clinic to verify the automated platelet count?
CKCS = Cavalier King Charles spaniel
Diagnosis
Inherited Macrothrombocytopenia
Platelets that are the same size as or larger than an erythrocyte are called macroplatelets or macrothrombocytes.1 Macroplatelets were identified in this patient (See Figures 1 and 2). While occasional macroplatelets can be present in normal dogs, increased numbers have been associated with certain breeds.1 CKCSs have a high prevalence of an inherited genetic mutation, which affects early platelet formation and results in an increased percentage of macroplatelets and thrombocytopenia; this clinical condition is termed inherited macrothrombocytopenia.2 The prevalence of inherited macrothrombocytopenia in the US population of CKCSs is reported to be 30% to 50%.
It is important to note that these dogs may mistakenly be considered to have an underlying disease that results in thrombocytopenia, such as immune-mediated thrombocytopenia, tick-borne infection, or a bone marrow disorder. Unlike other dogs with platelet counts of 30,000/µL or lower, CKCSs with the mutation do not have signs of spontaneous mucocutaneous hemorrhage because their overall platelet function is normal.2,3 Platelet function is believed to depend more on total platelet mass (number × volume) than platelet number alone. The platelet mass of CKCSs with inherited macrothrombocytopenia is reportedly similar to CKCSs without the mutation (normal platelet count and no large platelets).4,5
The presence of macroplatelets can also reflect increased platelet production, with marrow release of large, immature platelets in response to ongoing or resolving thrombocytopenia. In addition, feline platelets are more variable in size than other domestic species, and healthy cats often have macroplatelets.1
Patient blood smear. (Wright-Giemsa stain; 500× original magnification)
Systems & Techniques
Note variation in platelet size. One macroplatelet is approximately 2× the size of an erythrocyte (black arrow). A segmented neutrophil is present in the top left corner (red arrow). (Wright-Giemsa stain; 1000× original magnification)
A potential problem with automated hematology systems (impedance and flow cytometry technology) is the reporting of falsely low platelet counts because the analyzer does not recognize, and therefore count, largeplatelets or individual platelets that comprise a clump. Some commercial hematology analyzers used at reference laboratories have reported better success at identifying large platelets, which would provide a more accurate platelet count and a better estimation of platelet mass.<sup5 sup>
In addition, a manual platelet count may be performed at some reference laboratories, using a hemocytometer. If platelet clumps are identified in the hemocytometer counting chamber, the technician can roughly estimate how many platelets are comprised within the clump as well as identify macroplatelets.

Feline blood smear; note large platelet clumps along the feathered edge of the smear (arrows). (Wright-Giemsa stain; 100× original magnification)
Unfortunately, the technique of performing a manual platelet count requires practice, which may not be a practical option for most clinics. For this case, a manual count was performed and reported as 66,000/µL, markedly increased from the impedance automated analyzer platelet count of 2350/µL but still consistent with thrombocytopenia. Using manual platelet counts or hematology instruments that utilize flow cytometry, reported platelet counts in healthy CKCSs with the mutation (without evidence of bleeding) have been reported to range from 30,000 to 200,000/µL.4,2
In practice, the best way to verify an automated platelet count is to perform a blood smear platelet estimate. Platelet estimation should be performed on a blood smear made from a freshly collected blood sample, ideally obtained by nontraumatic venipuncture, as platelets can become activated and clump as the blood is flowing from the vessel into the syringe or collection tube.
Estimation & Identification
Platelet estimation should begin by evaluating the feathered edge of the smear for platelet clumps using the 10× objective (See Figure 3), which can lead to an underestimation of the platelet count. Next, the blood smear monolayer should be identified with the 10× objective. The monolayer of the blood smear is the area directly behind the feathered edge, where red cells touch occasionally but do not pile on top of one another (Figure 4). Once the monolayer has been identified, a drop of immersion oil is placed on the slide and the 100× oil objective is used to screen 10 separate viewing fields. A new viewing field should only require a subtle directional movement of the slide, but each viewing field should represent an entirely new area of the slide that is still within the monolayer.
Platelets are usually 25% to 50% the size of an erythrocyte and have light blue to gray cytoplasm with irregular edges, or sometimes spiderlike cytoplasm extensions.6 Platelets will often have bright magenta granules but some platelets may appear degranulated, which likely reflects recent activation.<sup1 sup>
Blood smear from a dog without macrothrombocytopenia and a normal hematocrit and platelet count. This image represents the blood smear monolayer, and platelets are significantly smaller than surrounding erythrocytes. (Wright-Giemsa stain; 500× original magnification)
The average number of platelets per 10 fields is multiplied by 20,000 to give a final estimate of the number of platelets per microliter. The normal platelet count for dogs and cats is approximately 200,000 to 500,000 platelets/µL. If 200,000/µL is divided by the conversion factor of 20,000, the result is 10 platelets per field using the 100× oil objective.
Related Article: Feline Hematologic Disorder
Follow-up
As the dog did not have signs to suggest an underlying bleeding disorder or a hypercoagulative state, thrombocytopenia and macroplatelets were presumed to be a result of inherited macrothrombocytopenia. The dog was also diagnosed with a cranial cruciate tear of the left stifle.
Did You Answer...
Approximately 30% to 50% of the US CKCS population has inherited macrothrombocytopenia.
Automated hematology analyzers may not recognize and count large platelets and platelet clumps, resulting in a falsely decreased platelet count.
A platelet estimate could be completed from a blood smear to verify automated platelet counts.
SARAH SCHMIDT, DVM, is a lecturer at Tufts Cummings School of Veterinary Medicine where she is completing her residency in clinical pathology. Prior, she was a general small animal practitioner for 6 years. She earned her DVM from University of Florida.